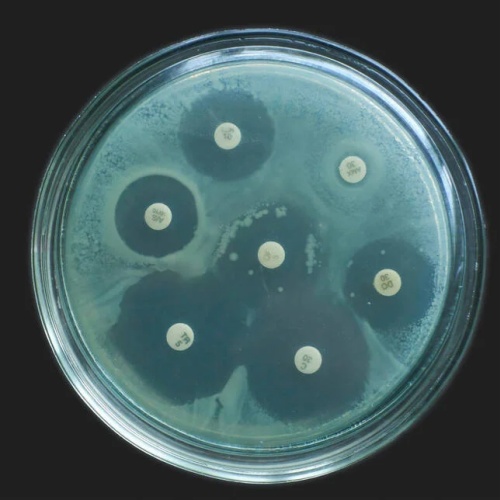

一、研究背景:熟悉的药物,新的问题
Ibuprofen(布洛芬)和Paracetamol(对乙酰氨基酚)是全球最常用的止痛退烧药之一。它们之所以广泛使用,除了疗效确切外,还因为在许多国家可以作为非处方药(OTC)直接购买。
然而,这些看似“安全常用”的药物,是否可能在无意中促进抗生素耐药的产生?这一问题引起了科研人员的关注。一项由澳大利亚研究团队完成、发表于顶级期刊Nature的研究,给出了值得警惕的答案。
二、抗生素耐药:不仅仅是抗生素的问题
长期以来,人们普遍认为抗生素耐药(Antibiotic Resistance, ABR)主要由以下因素驱动:
抗生素滥用或过度使用,
人类医疗和畜牧业中的不合理用药。
但近年来研究发现,非抗生素类药物(NAM)也可能参与其中,例如:利尿剂,他汀类药物,质子泵抑制剂(PPI)。
这些药物虽然不直接杀菌,但可能:对肠道菌群产生类似抗生素的影响,诱导细菌发生适应性改变。
三、耐药形成的潜在机制
非抗生素药物可能通过多种途径促进耐药性产生:
1.诱导基因突变
改变细菌遗传结构,使其更容易耐药。
2.交叉耐药(Cross-resistance)
一种药物诱导的耐受性,影响另一类药物。
3.水平基因转移
例如通过质粒交换获得耐药基因。
此外,环境因素也不容忽视。例如:药物在污水中无法完全降解,不同药物(如Ciprofloxacin和Tramadol)在环境中相互作用,可能促进耐药菌的传播。
四、研究设计:聚焦常用药物与细菌变化
该研究由澳大利亚University of South Australia的科研团队开展,主要通过体外实验(实验室细胞培养)进行。
研究重点:
观察非抗生素药物是否影响大肠杆菌(E. coli)对抗生素的敏感性,
重点分析与Ciprofloxacin(环丙沙星)的相互作用。
纳入研究的常见药物包括:Paracetamol,Ibuprofen,Diclofenac,Furosemide,Atorvastatin,Metformin,Pseudoephedrine,Temazepam,Tramadol。
这些药物在老年人群(多重用药)中尤为常见。
五、关键研究发现
1. 促进细菌“适应能力”增强
研究发现,部分非抗生素药物可以:提高大肠杆菌的生长速度,增加其最大细胞密度,提升整体“生存能力”(fitness)。
2. 显著提高抗生素耐药性
在与Ciprofloxacin联合暴露时:
Atorvastatin + Ciprofloxacin:耐药性增加约8倍,
Ibuprofen + Ciprofloxacin:耐药性增加约8倍,
Paracetamol + Ciprofloxacin:最高增加约16倍。
也就是说,抗生素需要更高剂量才能抑制细菌生长。
3. 多药联合风险更高
两种非抗生素药物联合使用时可使耐药性进一步增加2–4倍。
同时,还观察到对Levofloxacin(左氧氟沙星)的耐药性也有所上升。
六、为何这一发现值得重视?
该研究提示:
常见止痛药可能并非“完全中性”,
在特定条件下可能影响抗生素疗效,
尤其是在多重用药(polypharmacy)人群中风险更高。
例如:老年护理机构中患者常长期使用多种药物,同时接受抗生素治疗。
这种组合正是研究中模拟的情况之一。
七、研究局限性
需要强调的是:该研究属于体外实验(细胞培养),尚不能完全等同于人体真实情况。
因此,目前不能得出结论认为:“服用止痛药会直接导致耐药感染”。但它为后续研究提供了重要方向。
八、专家观点与临床启示
研究作者之一Henrietta Venter指出:抗生素耐药问题,已经不再只是抗生素本身的问题。
这项研究强调:
在临床用药中,需要关注多种药物之间的相互作用,
尤其是在老年医学领域,
不应只考虑“两种药物”的相互作用,而要关注整体用药组合。
九、我们该如何看待这一问题?
从当前证据来看,可以得出几个理性结论:
1.无需恐慌
常用止痛药仍然是安全有效的基础用药。
2.避免不必要用药
不滥用止痛药或抗生素。
3.关注多重用药风险
尤其是老年人或慢性病患者。
4.遵医嘱使用抗生素
避免自行联合多种药物。
十、总结
这项研究提醒我们,抗生素耐药的形成机制比以往认识的更加复杂。除了抗生素本身,常见的非抗生素药物也可能在其中扮演“隐性角色”。
未来,随着研究深入,人们或将更加重视“整体用药生态”,而不仅仅是单一药物的作用。这对于合理用药、延缓耐药性发展具有重要意义。